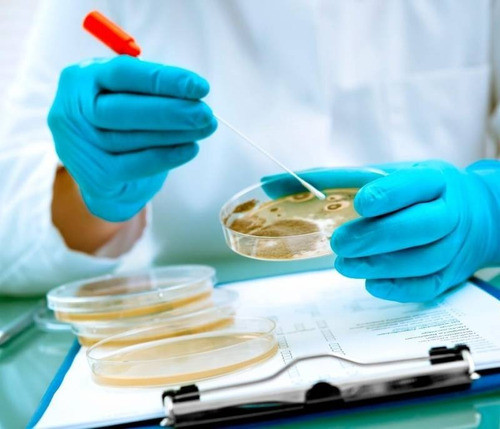
Placa De Petri Esteril Ps 60 X 15 Mm - Pack X 10 Und 1

Petri Dishes
Explore our extensive collection of high-quality Petri Dishes, ideal for microbiological studies and laboratory research. Our selection includes various sizes and materials to meet all your scientific needs, ensuring reliable results and durability. Perfect for both professionals and students in the field of biology and laboratory science.
- Product
- Qty in Cart
- Quantity
- Price
- Subtotal
-

Henso Portaobjetos Vidrio 1 X3 X 50 Unidades Biolinger
US $69.17 & eligible for FREE ShippingShop Portaobjetos Vidrio 1 X3 X 50 Unidades Biolinger and more Tubos de Ensayo at Latinafy.comDiscover the Henso Portaobjetos Vidrio, expertly designed for laboratory precision and utility. This professional-grade item comes in a set of 50 pieces, each...- SKU:
- MLA1160486371
- Shipping Time:
- Ships within 2-5 business days after your purchase. We will receive your product at our warehouse and carefully package it for international shipping.
- Weight:
- 1.30 KGS
- Origin:
- Argentina
- Vendor:
- Shop on Mercado Libre Argentina
- Brand:
- Henso Medical Co. Ltd.
US $69.17 & eligible for FREE Shipping -

Bioplast Square Petri Dish 120 X 120 Sterile Bag Of 10
US $95.95 & eligible for FREE ShippingShop Placa De Petri Cuadrada 120 X 120 Estéril Bolsa X 10u. and more Tubos de Ensayo at Latinafy.comIntroducing the Bioplast Square Petri Dishes, meticulously designed for your laboratory and research needs. Each dish measures 120 x 120 mm and is...- SKU:
- MLA1660602926
- Shipping Time:
- Ships within 2-5 business days after your purchase. We will receive your product at our warehouse and carefully package it for international shipping.
- Weight:
- 0.65 KGS
- Origin:
- Argentina
- Vendor:
- Shop on Mercado Libre Argentina
- Brand:
- Bioplast
US $95.95 & eligible for FREE Shipping -


Ronyes Lifescience Glass Petri Dish Petri Plates Tissue Culture Plate 5 Pcs (90 Mm)
US $281.41 & eligible for FREE ShippingShop Placa De Petri De Vidrio Con Tapa 90 Mm - 5 Piezas. and more Puertas at Latinafy.comDiscover the versatility of Ronyes Lifescience's Glass Petri Dish set, featuring five 90mm dishes designed for various scientific applications. Made from durable,...- SKU:
- MLU626182333
- Shipping Time:
- Ships within 2-5 business days after your purchase. We will receive your product at our warehouse and carefully package it for international shipping.
- Weight:
- 0.65 KGS
- Origin:
- Uruguay
- Vendor:
- Shop on Mercado Libre Uruguay
- Brand:
- Ronyes Lifescience
US $281.41 & eligible for FREE Shipping -


Gasana Sterile Container 300cc Pack of 20 Units
US $151.12 & eligible for FREE ShippingShop Recipiente Esteril Gasana 300cc Estuchado X 20 Unidades and more Otros at Latinafy.comIntroducing the Gasana Sterile Disposable Container, designed for in vitro diagnostics with a capacity of 300cc. Each pack includes 20 units, ensuring a sufficient...- SKU:
- MLA1438858469
- Shipping Time:
- Ships within 2-5 business days after your purchase. We will receive your product at our warehouse and carefully package it for international shipping.
- Weight:
- 1.95 KGS
- Origin:
- Argentina
- Vendor:
- Shop on Mercado Libre Argentina
- Brand:
- Gasana
US $151.12 & eligible for FREE Shipping -

Plastic Petri Dish 55x15mm Sterile X 500 Units
US $543.15 & eligible for FREE ShippingShop Caja Placa De Petri Plástico 55x15mm Estéril X 500 Unidades and more Tubos de Ensayo at Latinafy.comIntroducing premium quality Petri dishes made from high-grade polystyrene, ideal for industrial use. Each dish is optically clear, allowing for...- SKU:
- MLA1666027088
- Shipping Time:
- Ships within 2-5 business days after your purchase. We will receive your product at our warehouse and carefully package it for international shipping.
- Weight:
- 4.55 KGS
- Origin:
- Argentina
- Vendor:
- Shop on Mercado Libre Argentina
- Brand:
- Unbranded
US $543.15 & eligible for FREE Shipping -

Biopetri Sterile Petri Dish 90x15mm x 25 Units
US $66.46 & eligible for FREE ShippingShop Placa De Petri Estéril 90x15mm X 25 Unidades and more Tubos de Ensayo at Latinafy.comDiscover the reliability of Biopetri Sterile Petri Dishes, expertly designed for your laboratory needs. Each dish measures 90 mm in diameter and 15 mm in height,...- SKU:
- MLA1816371140
- Shipping Time:
- Ships within 2-5 business days after your purchase. We will receive your product at our warehouse and carefully package it for international shipping.
- Weight:
- 0.65 KGS
- Origin:
- Argentina
- Vendor:
- Shop on Mercado Libre Argentina
- Brand:
- Biopetri
US $66.46 & eligible for FREE Shipping -


HENSO Sterile Petri Dish 35 x 15 mm - Pack of 10
US $59.94 & eligible for FREE ShippingShop Placa De Petri Esteril Ps 35 X 15 Mm - Pack X 10 Und and more Tubos de Ensayo at Latinafy.comIntroducing the HENSO Sterile Petri Dish, perfect for your laboratory needs. Each dish features a 35mm diameter and a height of 15mm, making them ideal for...- SKU:
- MLA1446478699
- Shipping Time:
- Ships within 2-5 business days after your purchase. We will receive your product at our warehouse and carefully package it for international shipping.
- Weight:
- 0.26 KGS
- Origin:
- Argentina
- Vendor:
- Shop on Mercado Libre Argentina
- Brand:
- Henso
US $59.94 & eligible for FREE Shipping -


Hamiggaa Pack of 30 Plastic Petri Dishes 90 x 15mm with Lids
US $165.55 & eligible for FREE ShippingShop Pack De 30 Placas De Petri De Plastico De 90 X 15mm Con Tapa and more Pipetas de Laboratorio at Latinafy.comDiscover the perfect addition to your laboratory or classroom with this pack of 30 high-quality plastic petri dishes. Each dish measures 90 x...- SKU:
- MLU624788188
- Shipping Time:
- Ships within 2-5 business days after your purchase. We will receive your product at our warehouse and carefully package it for international shipping.
- Weight:
- 1.56 KGS
- Origin:
- Uruguay
- Vendor:
- Shop on Mercado Libre Uruguay
- Brand:
- Hamiggaa
US $165.55 & eligible for FREE Shipping -


Biopetri Sterile Petri Dish 90x15mm Box of 500 Units
US $484.40 & eligible for FREE ShippingShop Placa Petri Estéril 90x15mm Caja X 500 Unidades and more Tubos de Ensayo at Latinafy.comIntroducing the Biopetri Sterile Petri Dishes, designed for precision and reliability in every experiment. Each dish measures 90x15 mm, providing ample space for...- SKU:
- MLA923411361
- Shipping Time:
- Ships within 2-5 business days after your purchase. We will receive your product at our warehouse and carefully package it for international shipping.
- Weight:
- 6.50 KGS
- Origin:
- Argentina
- Vendor:
- Shop on Mercado Libre Argentina
- Brand:
- Biopetri
US $484.40 & eligible for FREE Shipping -


Anumbra 10 Petri Dishes 60x15 Mm Borosilicate Glass
US $170.37 & eligible for FREE ShippingShop 10 Capsulas De Petri 60x15 Mm Vidrio Boro 3.3 - Anumbra and more Tubos de Ensayo at Latinafy.comIntroducing a pack of 10 premium-quality Petri dishes by Anumbra, measuring 60x15 mm, crafted from durable borosilicate glass. These new, unused Petri...- SKU:
- MLA1255584297
- Shipping Time:
- Ships within 2-5 business days after your purchase. We will receive your product at our warehouse and carefully package it for international shipping.
- Weight:
- 0.65 KGS
- Origin:
- Argentina
- Vendor:
- Shop on Mercado Libre Argentina
- Brand:
- Anumbra
US $170.37 & eligible for FREE Shipping -


Everglass Frosted Object Slides - 5 Boxes of 50 Units Each
US $121.81 & eligible for FREE ShippingShop Portaobjeto B.esmerilado Frosted 5 Cajas X50u C/u Everglass and more Tubos de Ensayo at Latinafy.comDiscover the premium Everglass Frosted Object Slides, the perfect solution for your laboratory needs. Each purchase includes five boxes, with 50...- SKU:
- MLA1214806649
- Shipping Time:
- Ships within 2-5 business days after your purchase. We will receive your product at our warehouse and carefully package it for international shipping.
- Weight:
- 1.95 KGS
- Origin:
- Argentina
- Vendor:
- Shop on Mercado Libre Argentina
- Brand:
- Everglass
US $121.81 & eligible for FREE Shipping -

Henso Medical 90x15mm Borosilicate Petri Dish - Pack of 10
US $201.63 & eligible for FREE ShippingShop Placa De Petri 90x15mm Vidrio Borosilicato X 10 Unid. and more Tubos de Ensayo at Latinafy.comDiscover the premium quality of Henso's 90x15mm borosilicate petri dishes. Designed for professional laboratory environments, these dishes are...- SKU:
- MLA1544798474
- Shipping Time:
- Ships within 2-5 business days after your purchase. We will receive your product at our warehouse and carefully package it for international shipping.
- Weight:
- 1.30 KGS
- Origin:
- Argentina
- Vendor:
- Shop on Mercado Libre Argentina
- Brand:
- Henso Medical Co. Ltd.
US $201.63 & eligible for FREE Shipping -


Normax 10 Pieces of Borosilicate Glass Petri Dishes 150x25mm
US $273.50 & eligible for FREE ShippingShop 10 Peças De Placas De Petri De Vidro Boro 150x25mm and more Copos Becker at Latinafy.comEnsure successful microbiological experiments with our 10-pack of Normax Petri Dishes, designed for durability and reliability. Each dish measures 150x25mm,...- SKU:
- MLB3856756146
- Shipping Time:
- Ships within 2-5 business days after your purchase. We will receive your product at our warehouse and carefully package it for international shipping.
- Weight:
- 1.95 KGS
- Origin:
- Brazil
- Vendor:
- Shop on Mercado Libre Brazil
- Brand:
- Normax
US $273.50 & eligible for FREE Shipping -


Henso Medical Co.,Ltd Petri Dish Capsule Box 60 Mm Borosilicate Glass 3.3 X 10u
US $116.35 & eligible for FREE ShippingShop Caja Placa Cápsula Petri 60 Mm Vidrio Borosilicato 3.3 X 10u and more Tubos de Ensayo at Latinafy.comElevate your laboratory experience with these high-quality Petri dishes made from premium borosilicate glass. Each dish is designed to withstand...- SKU:
- MLA1443986504
- Shipping Time:
- Ships within 2-5 business days after your purchase. We will receive your product at our warehouse and carefully package it for international shipping.
- Weight:
- 0.65 KGS
- Origin:
- Argentina
- Vendor:
- Shop on Mercado Libre Argentina
- Brand:
- Henso Medical Co.,Ltd
US $116.35 & eligible for FREE Shipping -


Bioplast Petri Dish 90x15mm Sterile Pack of 25 Units
US $72.22 & eligible for FREE ShippingShop Placa De Petri Plastico 90x15mm Estéril Pack X 25 Unidades and more Tubos de Ensayo at Latinafy.comExperience precision with Bioplast's Petri Dishes, designed for optimal microbiological applications. Each dish measures 90x15 mm and comes sterilized...- SKU:
- MLA1230542045
- Shipping Time:
- Ships within 2-5 business days after your purchase. We will receive your product at our warehouse and carefully package it for international shipping.
- Weight:
- 0.65 KGS
- Origin:
- Argentina
- Vendor:
- Shop on Mercado Libre Argentina
- Brand:
- Bioplast
US $72.22 & eligible for FREE Shipping -


Henso Medical Plastic Petri Dish 60x15mm Sterile X 10 Units
US $53.89 & eligible for FREE ShippingShop Caja Placa De Petri Plástico 60x15mm Estéril X 10 Unid and more Tubos de Ensayo at Latinafy.comThese high-quality polystyrene Petri dishes are designed for superior performance in laboratory settings. With an optical transparency that allows for...- SKU:
- MLA836740509
- Shipping Time:
- Ships within 2-5 business days after your purchase. We will receive your product at our warehouse and carefully package it for international shipping.
- Weight:
- 0.39 KGS
- Origin:
- Argentina
- Vendor:
- Shop on Mercado Libre Argentina
- Brand:
- Henso Medical
US $53.89 & eligible for FREE Shipping -

Paralwall Cell Culture Plate 6 Wells DNAsa/RNAsa Free
US $77.81 & eligible for FREE ShippingShop Placa Cultivo Celular 6 Hoyos Dnasa/rnasa Free Paralwall and more Tubos de Ensayo at Latinafy.comIntroducing the Paralwall Cell Culture Plate, designed specifically for your laboratory needs. This innovative 6-well plate is manufactured from...- SKU:
- MLA1628256560
- Shipping Time:
- Ships within 2-5 business days after your purchase. We will receive your product at our warehouse and carefully package it for international shipping.
- Weight:
- 0.13 KGS
- Origin:
- Argentina
- Vendor:
- Shop on Mercado Libre Argentina
- Brand:
- Paralwall
US $77.81 & eligible for FREE Shipping -

Paralwall Sterile Petri Dish 60 X 15 Mm - Pack of 10
US $65.12 & eligible for FREE ShippingShop Placa De Petri Esteril Ps 60 X 15 Mm - Pack X 10 Und and more Tubos de Ensayo at Latinafy.comExperience unmatched quality with the Paralwall Sterile Petri Dishes, measuring 60 mm in diameter and 15 mm in height. Each pack contains 10 units, perfect...- SKU:
- MLA1501377302
- Shipping Time:
- Ships within 2-5 business days after your purchase. We will receive your product at our warehouse and carefully package it for international shipping.
- Weight:
- 0.65 KGS
- Origin:
- Argentina
- Vendor:
- Shop on Mercado Libre Argentina
- Brand:
- Paralwall
US $65.12 & eligible for FREE Shipping -


HDA Coverslips 20x20mm (Pack of 100)
US $61.36 & eligible for FREE ShippingShop Cubreobjetos Vidrio 20x20mm (x 100un) and more Tubos de Ensayo at Latinafy.comDiscover the exceptional quality of HDA coverslips, measuring 20 x 20 mm and available in a convenient pack of 100. Each coverslip is made from high-quality glass with a...- SKU:
- MLA1380530575
- Shipping Time:
- Ships within 2-5 business days after your purchase. We will receive your product at our warehouse and carefully package it for international shipping.
- Weight:
- 1.30 KGS
- Origin:
- Argentina
- Vendor:
- Shop on Mercado Libre Argentina
- Brand:
- Hda
US $61.36 & eligible for FREE Shipping -


Biologix Petri Dishes, 60 mm, Sterile, Pack of 30
US $90.02 & eligible for FREE ShippingShop Placas De Petri, 60 Mm, Estériles, Pack X30, Marca Biologix and more Tubos de Ensayo at Latinafy.comDiscover the premium quality of Biologix Petri Dishes, specifically designed for precise laboratory use. Each dish measures 60 mm in diameter and 15...- SKU:
- MLU475113225
- Shipping Time:
- Ships within 2-5 business days after your purchase. We will receive your product at our warehouse and carefully package it for international shipping.
- Weight:
- 0.65 KGS
- Origin:
- Uruguay
- Vendor:
- Shop on Mercado Libre Uruguay
- Brand:
- Biologix
US $90.02 & eligible for FREE Shipping -

MASSOBACT Plastic Petri Dish 90x15mm Sterile Disposable Pack of 100
US $153.62 & eligible for FREE ShippingShop Placa Petri Plástica 90x15mm Estéril Descartable Pack X 100u and more Tubos de Ensayo at Latinafy.comDiscover the reliability of MASSOBACT's 90x15mm Plastic Petri Dishes, designed for precision and sterility. Each dish is disposable, ensuring...- SKU:
- MLA921329849
- Shipping Time:
- Ships within 2-5 business days after your purchase. We will receive your product at our warehouse and carefully package it for international shipping.
- Weight:
- 1.56 KGS
- Origin:
- Argentina
- Vendor:
- Shop on Mercado Libre Argentina
- Brand:
- Massobact
US $153.62 & eligible for FREE Shipping -


Normax Glass Petri Dish 90x15mm with 10 Units
US $146.99 & eligible for FREE ShippingShop Placa De Petri De Vidro 90x15 C/ 10 Unidades and more Erlenmeyers at Latinafy.comIntroducing the Normax Glass Petri Dish set, expertly crafted for your laboratory needs. This combo includes 10 premium glass Petri dishes, each measuring 90x15mm,...- SKU:
- MLB5073172810
- Shipping Time:
- Ships within 2-5 business days after your purchase. We will receive your product at our warehouse and carefully package it for international shipping.
- Weight:
- 1.95 KGS
- Origin:
- Brazil
- Vendor:
- Shop on Mercado Libre Brazil
- Brand:
- Normax
US $146.99 & eligible for FREE Shipping -


Biologix Petri Dishes, 35mm, Sterile, Pack of 30
US $99.98 & eligible for FREE ShippingShop Placas De Petri, 35 Mm, Estériles, Pack X30, Marca Biologix and more Tubos de Ensayo at Latinafy.comDiscover the exceptional quality of Biologix Petri Dishes, designed for precision in scientific research. These 35 mm sterile plates ensure a...- SKU:
- MLU644483427
- Shipping Time:
- Ships within 2-5 business days after your purchase. We will receive your product at our warehouse and carefully package it for international shipping.
- Weight:
- 0.65 KGS
- Origin:
- Uruguay
- Vendor:
- Shop on Mercado Libre Uruguay
- Brand:
- Biologix
US $99.98 & eligible for FREE Shipping -


Normax 5 Units Petri Dish 60x15mm Glass
US $79.58 & eligible for FREE ShippingShop Melhor Preço 5 Unidades Placa De Petri 60x15mm De Vidro and more Copos Becker at Latinafy.comDiscover the perfect solution for your microbial cultivation needs with our Normax Petri Dishes. Each set contains 5 high-quality dishes measuring 60x15mm,...- SKU:
- MLB3405770109
- Shipping Time:
- Ships within 2-5 business days after your purchase. We will receive your product at our warehouse and carefully package it for international shipping.
- Weight:
- 0.65 KGS
- Origin:
- Brazil
- Vendor:
- Shop on Mercado Libre Brazil
- Brand:
- Normax
US $79.58 & eligible for FREE Shipping -


Mellth Petri Dish Glass 60 X 15 Mm
US $51.33 & eligible for FREE ShippingShop Caja Petri Vidrio 60 X 15 Mm and more Otros at Latinafy.comDiscover the premium Mellth Petri Dish, crafted from high-quality borosilicate glass with reinforced walls. This exceptional glassware measures approximately 60 mm in diameter and 15 mm in...- SKU:
- MLA918699312
- Shipping Time:
- Ships within 2-5 business days after your purchase. We will receive your product at our warehouse and carefully package it for international shipping.
- Weight:
- 0.13 KGS
- Origin:
- Argentina
- Vendor:
- Shop on Mercado Libre Argentina
- Brand:
- Mellth
US $51.33 & eligible for FREE Shipping -


Joanlab Plastic Petri Dish 60x15mm, 17g, Sterile X 104 Units
US $141.71 & eligible for FREE ShippingShop Placa De Petri Plástico 60x15mm, 17g, Estéril X 104 Unidades and more Tubos de Ensayo at Latinafy.comExplore our high-quality Joanlab plastic Petri dishes, perfect for laboratory needs. Each dish measures 60 mm in diameter and is crafted from...- SKU:
- MLA1805867946
- Shipping Time:
- Ships within 2-5 business days after your purchase. We will receive your product at our warehouse and carefully package it for international shipping.
- Weight:
- 2.34 KGS
- Origin:
- Argentina
- Vendor:
- Shop on Mercado Libre Argentina
- Brand:
- Joanlab
US $141.71 & eligible for FREE Shipping -


BIOLINGER Plastic Petri Dish 90x15mm Sterile X 100 Units
US $156.43 & eligible for FREE ShippingShop Placa De Petri Plástica 90x15mm Estéril X 100 Unidades and more Tubos de Ensayo at Latinafy.comDiscover the superior quality of BIOLINGER's Plastic Petri Dishes, measuring 90x15mm and designed for versatile lab applications. Each dish is sterilized...- SKU:
- MLA1168299562
- Shipping Time:
- Ships within 2-5 business days after your purchase. We will receive your product at our warehouse and carefully package it for international shipping.
- Weight:
- 1.30 KGS
- Origin:
- Argentina
- Vendor:
- Shop on Mercado Libre Argentina
- Brand:
- Biolinger
US $156.43 & eligible for FREE Shipping -

DAC Petri Dishes 55x15 with Magnifier and Indicator Ribbon - Pack of 100
US $236.46 & eligible for FREE ShippingShop Placas De Petri 55x15 Con Lupa Y Faja Indicadora X 100u and more Tubos de Ensayo at Latinafy.comDiscover the high-quality DAC Petri Dishes designed for laboratory precision and efficiency. Each set contains plastic, sterile Petri dishes, perfectly...- SKU:
- MLA1805819860
- Shipping Time:
- Ships within 2-5 business days after your purchase. We will receive your product at our warehouse and carefully package it for international shipping.
- Weight:
- 1.95 KGS
- Origin:
- Argentina
- Vendor:
- Shop on Mercado Libre Argentina
- Brand:
- Dac
US $236.46 & eligible for FREE Shipping -


Bioart Rigid Plates 1mm (0.04) X 5u
US $72.10 & eligible for FREE ShippingShop Placas Rigidas 1mm (0.04) X 5u Bioart Termoformadora and more Otros at Latinafy.comIntroducing Bioart's Rigid Plates designed for thermoforming, packaged vacuum-sealed and bubble-free for quality assurance. Each package contains five durable 1mm...- SKU:
- MLA839203014
- Shipping Time:
- Ships within 2-5 business days after your purchase. We will receive your product at our warehouse and carefully package it for international shipping.
- Weight:
- 0.29 KGS
- Origin:
- Argentina
- Vendor:
- Shop on Mercado Libre Argentina
- Brand:
- Bioart
US $72.10 & eligible for FREE Shipping -


Henso Plastic Sterile Disposable Petri Dish 60x15mm - Pack of 10
US $73.86 & eligible for FREE ShippingShop Placa De Petri 60x15mm Plástica Estéril Descartable X 10un. and more Tubos de Ensayo at Latinafy.comDiscover our premium Henso plastic sterile disposable petri dishes, specifically designed for laboratory use. Each pack contains 10 units of 60x15mm...- SKU:
- MLA856712824
- Shipping Time:
- Ships within 2-5 business days after your purchase. We will receive your product at our warehouse and carefully package it for international shipping.
- Weight:
- 0.65 KGS
- Origin:
- Argentina
- Vendor:
- Shop on Mercado Libre Argentina
- Brand:
- Henso
US $73.86 & eligible for FREE Shipping -

Whatman General Use Laboratory Filter Paper 125 Mm 100 Discs
US $81.07 & eligible for FREE ShippingShop Papel De Filtro Uso General Laboratorio 125 Mm 100 Discos and more Otros at Latinafy.comDiscover the premium quality of Whatman filter paper, designed specifically for laboratory use. These qualitative filter papers measure 125 mm in diameter and...- SKU:
- MLA930014493
- Shipping Time:
- Ships within 2-5 business days after your purchase. We will receive your product at our warehouse and carefully package it for international shipping.
- Weight:
- 0.65 KGS
- Origin:
- Argentina
- Vendor:
- Shop on Mercado Libre Argentina
- Brand:
- Whatman
US $81.07 & eligible for FREE Shipping -

MASSOBACT Sterile Disposable Plastic Petri Dish 90x15mm Pack of 100
US $163.26 & eligible for FREE ShippingShop Placa Petri Plástica 90x15mm Estéril Descartable Pack X 100u and more Tubos de Ensayo at Latinafy.comDiscover the convenience of the MASSOBACT Sterile Disposable Plastic Petri Dishes, measuring 90x15mm. Each dish is sterilized using ethylene oxide,...- SKU:
- MLA763948709
- Shipping Time:
- Ships within 2-5 business days after your purchase. We will receive your product at our warehouse and carefully package it for international shipping.
- Weight:
- 1.56 KGS
- Origin:
- Argentina
- Vendor:
- Shop on Mercado Libre Argentina
- Brand:
- Massobact
US $163.26 & eligible for FREE Shipping -

Biopetri Sterile Petri Dish 90 X 15mm X 100 Units
US $141.17 & eligible for FREE ShippingShop Placa De Petri Estéril 90 X 15mm X 100 Unidades and more Tubos de Ensayo at Latinafy.comDiscover the ideal solution for your laboratory needs with the Biopetri Sterile Petri Dish. Measuring 90 x 15 mm, these dishes come in a convenient pack of 100,...- SKU:
- MLA1399601097
- Shipping Time:
- Ships within 2-5 business days after your purchase. We will receive your product at our warehouse and carefully package it for international shipping.
- Weight:
- 1.56 KGS
- Origin:
- Argentina
- Vendor:
- Shop on Mercado Libre Argentina
- Brand:
- Biopetri
US $141.17 & eligible for FREE Shipping -


Henso Medical Co.,Ltd Petri Dish 100 Mm Borosilicate Glass 3.3
US $66.98 & eligible for FREE ShippingShop Caja Placa Cápsula Petri 100 Mm Vidrio Borosilicato 3.3 and more Tubos de Ensayo at Latinafy.comExperience precision and durability with the Henso Medical Co.,Ltd Petri Dish made from high-quality borosilicate glass 3.3. Measuring 100 mm in diameter...- SKU:
- MLA1344824212
- Shipping Time:
- Ships within 2-5 business days after your purchase. We will receive your product at our warehouse and carefully package it for international shipping.
- Weight:
- 0.26 KGS
- Origin:
- Argentina
- Vendor:
- Shop on Mercado Libre Argentina
- Brand:
- Henso Medical Co.,Ltd
US $66.98 & eligible for FREE Shipping -


Global Glass Combo Petri Dish 100x20mm - 20 Pieces
US $295.38 & eligible for FREE ShippingShop Combo Placa De Petri De Vidro 100x20mm - 20 Peças and more Copos Becker at Latinafy.comDiscover the unparalleled quality of our Global Glass Petri Dishes, each measuring 100x20mm. This combo package includes 20 new and original glass plates, perfect...- SKU:
- MLB3477780995
- Shipping Time:
- Ships within 2-5 business days after your purchase. We will receive your product at our warehouse and carefully package it for international shipping.
- Weight:
- 1.95 KGS
- Origin:
- Brazil
- Vendor:
- Shop on Mercado Libre Brazil
- Brand:
- Global Glass
US $295.38 & eligible for FREE Shipping -


Drop Glass 5 Pieces Glass Petri Dish 90x18mm with Lid
US $117.71 & eligible for FREE ShippingShop 5 Peças Placa De Petri Vidro 90x15mm Tampa Oferta Barato and more Copos Becker at Latinafy.comIntroducing the new Drop Glass Petri Dishes, perfect for all your laboratory needs. This kit includes 5 high-quality glass Petri dishes, offering superior...- SKU:
- MLB3311366860
- Shipping Time:
- Ships within 2-5 business days after your purchase. We will receive your product at our warehouse and carefully package it for international shipping.
- Weight:
- 1.35 KGS
- Origin:
- Brazil
- Vendor:
- Shop on Mercado Libre Brazil
- Brand:
- Drop
US $117.71 & eligible for FREE Shipping -


Normax Combo of 3 Petri Dishes 60x15mm Glass
US $75.81 & eligible for FREE ShippingShop Combo 3 Unidades Placa De Petri 60x15mm De Vidro and more Copos Becker at Latinafy.comIntroducing the Normax Combo of Petri Dishes, featuring three high-quality glass plates measuring 60x15mm each. Crafted from durable borosilicate glass, these...- SKU:
- MLB3381215773
- Shipping Time:
- Ships within 2-5 business days after your purchase. We will receive your product at our warehouse and carefully package it for international shipping.
- Weight:
- 0.65 KGS
- Origin:
- Brazil
- Vendor:
- Shop on Mercado Libre Brazil
- Brand:
- Normax
US $75.81 & eligible for FREE Shipping -


PLACA DE PETRI Incredible Offer Kit of 10 Glass Petri Dishes 150x25mm
US $260.80 & eligible for FREE ShippingShop Oferta Incrível Kit C/10 Placas Petri Vidro 150x25mm + Frete and more Copos Becker at Latinafy.comDiscover the essential tool for microbiology and laboratory experiments with our Kit of 10 Glass Petri Dishes. Each dish, measuring 150x25mm, is made...- SKU:
- MLB1964855362
- Shipping Time:
- Ships within 2-5 business days after your purchase. We will receive your product at our warehouse and carefully package it for international shipping.
- Weight:
- 1.95 KGS
- Origin:
- Brazil
- Vendor:
- Shop on Mercado Libre Brazil
- Brand:
- Placa De Petri
US $260.80 & eligible for FREE Shipping -


PLACA DE PETRI Glass Petri Dish 60x15mm - 10 Pieces Promotion
US $126.78 & eligible for FREE ShippingShop Placa De Petri Vidro 60x15mm 10 Peças Promoção and more Copos Becker at Latinafy.comExperience premium quality with our PLACA DE PETRI Glass Petri Dishes, designed for precision and reliability in laboratory settings. This promotion comes with 10...- SKU:
- MLB1614278326
- Shipping Time:
- Ships within 2-5 business days after your purchase. We will receive your product at our warehouse and carefully package it for international shipping.
- Weight:
- 1.30 KGS
- Origin:
- Brazil
- Vendor:
- Shop on Mercado Libre Brazil
- Brand:
- Placa De Petri
US $126.78 & eligible for FREE Shipping -


Boro Glass Petri Dish 90x15mm Kit with 10 Pieces
US $132.18 & eligible for FREE ShippingShop Placa De Petri Vidro 90x15mm Kit Com 10 Peças and more Copos Becker at Latinafy.comExplore our Boro glass petri dishes, a must-have for any laboratory or educational setting. This kit includes 10 perfectly crafted dishes, each measuring 90x15mm...- SKU:
- MLB3402095481
- Shipping Time:
- Ships within 2-5 business days after your purchase. We will receive your product at our warehouse and carefully package it for international shipping.
- Weight:
- 0.65 KGS
- Origin:
- Brazil
- Vendor:
- Shop on Mercado Libre Brazil
- Brand:
- Boro
US $132.18 & eligible for FREE Shipping
